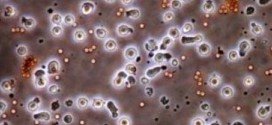

Evite a toda costa el consumo de productos torrefactados (como el café, malta, cacahuetes, almendras, maíz y semillas y pipas en general) y ahumados. Resumiendo: Ambas formas de preparación transforman el alimento en cancerígenos altamente peligrosos. Los fritos de carnes grasas deben ser proscritos, así como la parrilla para las carnes, pues dan lugar a sustancias mutágenas aún no identificadas …
Leer MásNoticias
LOS RITMOS CIRCADIANOS
La palabra circadiano significa «alrededor del día». Los ritmos circadianos son los acontecimientos rítmicos de diversas funciones del cuerpo en determinados momentos durante cada período de veinticuatro horas. Nadie pone en duda la existencia de tales ritmos, y existen muchísimos estudios de ellos, un vistazo al catálogo de cualquier biblioteca médica revela la existencia de centenares de libros sobre los …
Leer MásLA TEORÍA INTEGRAL U “HOLÍSTICA”
El buen funcionamiento de todo el organismo es la clave de la salud. Si el medio, en su totalidad, no está sano, la enfermedad es inevitable, y no se debe únicamente a la existencia del agente invasor, sino al desequilibrio y desnutrición del medio: “el todo”. La salud es un estado integral que se caracteriza por la estabilidad y el …
Leer MásEL BISMUTO
El bismuto, un metal pesado del que hasta ahora no se conoce ninguna función corporal de utilidad, produce también trastornos mentales. Se ha descubierto que la utilización de sales de bismuto o de preparados que contengan dicho mineral, como supositorios rectales, puede producir una intoxicación que se asemeja a la enfermedad mental. El uso oral repetido del bismuto en cual …
Leer MásLA TARTRAZINA
La tartrazina es un colorante amarillo sintético (E 102). Es necesario advertir contra el excesivo uso que en algunos hogares se hace de sucedáneos del azafrán, que nada tienen que ver con esta maravilla de planta y que se usan en paellas, arroces y guisos, mis paisanos los valencianos (comunidad valenciana) utilizan mucho el azafrán sintético ya que en esta …
Leer MásEL POLVO
El polvo de hoy no es el que limpiaban nuestras abuelas. Actualmente, junto sus componentes habituales, fragmentos de tierra, bacterias, moho, partículas de animales, etc, encontramos numerosas partículas de agentes contaminantes tales como sustancias cancerígenas de los humos de vehículos y tabaco, plomo, amianto, dióxido de azufre, aerosoles, plástico, productos de limpieza, radón procedente del cementos (un gas radioactivo), ambientadores …
Leer MásCOMER BIEN ES VIVIR BIEN
Por: Salvador Gregori Escrivá Nuestro cuerpo se nutre exclusivamente a través dos fuentes: la alimentación, que nos aporta la energía, antioxidantes, fitoquímicos esenciales, la energía y los elementos básicos para desarrollar nuestras funciones vitales, y la respiración, que nos proporciona el oxígeno necesario para la sobrevivencia. Resumiendo: El ser humano, al igual que todos los seres vivos que habitamos en …
Leer MásLA FALTA DE COMUNICACIÓN
Vivimos en una sociedad individualista y curiosamente solitaria. ¿A cuántas de las personas con las que hoy se ha cruzado por la calle, conocía usted, siquiera de vista? La masificación de las ciudades y la delincuencia nos ha llevado a convertirnos en seres desconfiados y faltos de comunicación. Si tiene usted la ocasión de visitar alguna vez algún pequeño pueblecito …
Leer MásPESTICIDAS Y CANCER
En la actualidad los investigadores están intentando medir los efectos de la polución global ocasionada por dichos pesticidas químicos. En estudios llevados a cabo en animales, la exposición a algunos de estos pesticidas induce el desarrollo de cáncer de mama, y ayuda al crecimiento y al desarrollo de los tumores en general. La mortalidad de las mujeres premenopáusicas a causa …
Leer MásDIAS DE SMOG
Con este término se denomina al conjunto de niebla, polución y humo producidos por las industrias y los residuos de los combustibles de los vehículos. Es una palabra inglesa que proviene de la unión del vocabulario smoke, que quiere decir humo, y fog, que quiere decir niebla. Las sustancias contenidas en el smog son partículas gaseosas y sólidas. Si se …
Leer MásCULTIVOS AL LADO DE LA CARRETERA
¡Deberían ser prohibidos! Todos hemos visto el polvo grisáceo, sucio, que se acumula a los lados de la carretera con fuerte tránsito. Si fijamos nuestra atención en una planta de malva que se esfuerza por sobrevivir entre una tapia y el borde de una carretera, veremos cómo apenas se aprecia el verde de sus hojas, sofocado por una capa de …
Leer MásLA CURA DEL LIMON EN PRIMAVERA
LA CURA DEL LIMÓN EN PRIMAVERA Por: Salvador Gregori Escrivá. Cofundador de la BINIPATIA y TROFOLOGIA/HIGIENISTA AVANZADA PERSONALIZADA. La cura del Limón es una forma de restablecer el equilibrio natural del cuerpo, depurar el organismo de toxinas, desintoxicar el hígado, alcalinizar la sangre y reforzar el sistema inmunológico, por mencionar sólo algunos de sus múltiples beneficios. Especialmente la cura del …
Leer MásFLOR DE LA PASIÓN
FLOR DE LA PASIÓN La Flor de la pasión, es originaria de Centroamérica, se encuentra con facilidad en jardines húmedos y de clima templado, recolectándose las flores en otoño. Es una planta herbácea perenne, con tallo provisto de zarcillos, hojas alternas, pecioladas y flores solitarias de cinco sépalos verdes y cinco pétalos blancos. Los filamentos forman una corola de color …
Leer MásACEITE DE HÍGADO DE BACALAO
El aceite de hígado de bacalao, es una excelente sustancia nutricional importante en su composición se encuentra: oleína, iodo, cloro, azufre, fósforo, bromo, butilamina, hexilamina, morruína, aselina, sales de dihidrolutidina, ácidos grasos poliinsaturados omega-3 (EPA y DHA), vitaminas A y D, etc. El aceite de hígado de bacalao goza de fama por los valores nutricionales. El aceite de hígado de …
Leer MásOMS destaca avances contra el cáncer en Cuba
La biotecnología es clave para transformar el cáncer de una enfermedad mortal a una crónica. Publicado en: binipatia.com Escrito por: Salvador Gregori y Barbara Gillan Etiquetas: sentido común, arsenal terapéutico alternativo Resumiendo: Muy bien que los pacientes sufran un montón no hay que curar hay que cronificar a los enfermos, para que curar es mejor que estén enfermos por vida muchísimo más …
Leer MásLeche el promotor de las enfermedades crónicas
Leche el promotor de las enfermedades crónicas occidentales. Resumen: Son comunes las enfermedades crónicas de las sociedades occidentales, tales como enfermedad cardíaca coronaria, diabetes mellitus, cáncer, hipertensión, obesidad, demencia, y enfermedades alérgicas son significativamente influenciadas por los hábitos alimenticios. La leche de vaca y los productos lácteos son alimentos básicos de nutrición en la mayoría de las sociedades occidentales. Consumo …
Leer MásLa Extirpación como una forma de «prevención»
Siguiendo de cerca los pasos de mayor intensidad anual del año de campañas de marketing de causa, Cáncer de Mama octubre el Mes de Concientización, dos acontecimientos escalofriantes que preocupan profundamente a las mujeres y su salud fueron ampliamente (pero sobre todo superficialmente) informó en los medios de comunicación. En primer lugar, Allyn Rose, Miss concursante Latina, anunció a principios …
Leer MásCodex Comité de Nutrición elige desnutrición
Scott Tips VRN discute con los delegados de Malasia y Benin en la reunión del CCNFSDU. En un impresionante despliegue de ignorancia nutricional, tres mujeres carnero a través de una norma del Codex que deja a muchos con sub-óptima nutrición. El Comité del Codex sobre Nutrición y Alimentos para Regímenes Especiales (CCNFSDU) acaba de cumplir toda la semana pasada (diciembre 3-7) …
Leer MásEL AZÚCAR Y EDULCORANTES
Los edulcorantes de azúcar y artificiales son tan accesibles, asequibles y sancionado socialmente, que pocos consideran que su consumo habitual de ser un problema en la escala de, por ejemplo, la adicción a la cocaína. Pero si la investigación reciente es correcta su potencial adictivo podría ser aún peor. Hace casi 40 años, William Duffy publicó un libro llamado Sugar …
Leer MásREFRANES Y DICHOS
Estos refranes y dichos tienen toda la verdad y razón de ser: “La vida duerme en el mineral, sueña en la planta, empieza a despertar en el animal y, está plenamente consciente en el hombre”. “Sangre, estómago, vientre y riñon, dependen de la alimentación”. “Quien como yo, solo de verduras, frutas, pan y agua se alimenta, no necesita de ayuda …
Leer Más Binipatia e higienismo Medicina natural alternativa, plantas medicinales y remedios caseros naturales
Binipatia e higienismo Medicina natural alternativa, plantas medicinales y remedios caseros naturales